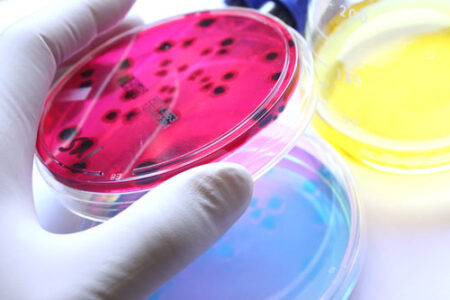
article image

Food poisoning is often regarded as a temporary spell of discomfort, lasting no more than a week or so. Recently published studies, however, have begun to paint a different picture. Scientific American (April 2012) reports on the findings of a study conducted on the Walkerton, Ontario outbreak of E. coli O157, wherein over 2,300 people were infected in May of 2000. Seeking to better understand the implications of the episode, the Ontario government set up the Walkerton Health Study and the results are alarming.
As the article states, residents who endured several days of diarrhea, compared with milder cases, had a 33 percent greater likelihood of developing high blood pressure, a 210 percent greater risk of heart attack or stroke, and a 340 percent greater risk of kidney problems in the eight years following the outbreak. Perhaps even more surprising is that long-term circulatory problems were observed in those who suffered only minor symptoms of E. coli O157.
So what can be done to prevent the long-lasting effects of food poisoning? For now, the best proposed medicine is knowing what to check for when seeing your doctor. The leader of the Walkerton Health Study, William F. Clark, suggests getting your blood pressure checked each year and having your kidney function assessed every two to three years. Hopes for better preventative care now rest in the results of future studies on the matter. The FDA recently gave a grant to the Center for Foodborne Illness Research and Prevention for research on how to best study the frequency of persistent aftereffects. Barbara Kowalcyk, the center’s cofounder, states, “As long as we focus only on the acute form of foodborne illness and not the long-term health consequences, we’ll underestimate how significant a problem this is.”